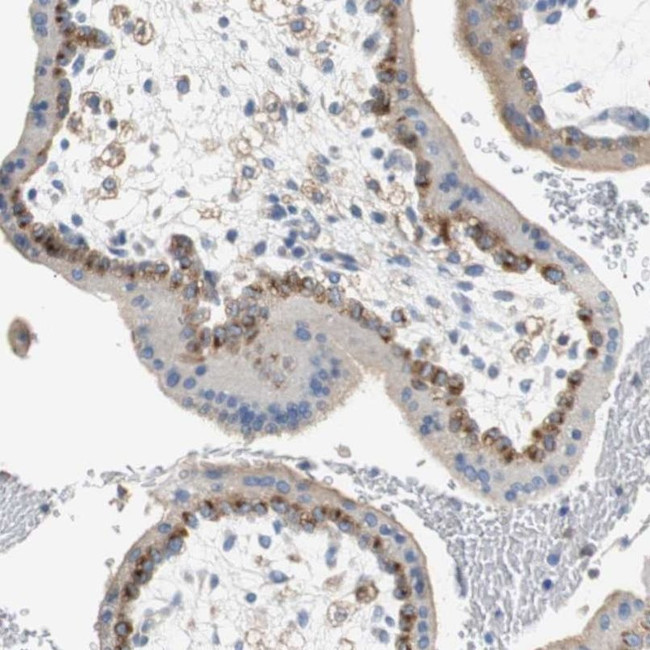
VAMP8 Antibody in Immunohistochemistry (IHC)

Search
Invitrogen
VAMP8 Polyclonal Antibody
{{$productOrderCtrl.translations['antibody.pdp.commerceCard.promotion.promotions']}}
{{$productOrderCtrl.translations['antibody.pdp.commerceCard.promotion.viewpromo']}}
{{$productOrderCtrl.translations['antibody.pdp.commerceCard.promotion.promocode']}}: {{promo.promoCode}} {{promo.promoTitle}} {{promo.promoDescription}}. {{$productOrderCtrl.translations['antibody.pdp.commerceCard.promotion.learnmore']}}
产品信息
PA5-52358
种属反应
宿主/亚型
分类
类型
抗原
偶联物
形式
浓度
规格
纯化类型
保存液
内含物
保存条件
运输条件
RRID
产品详细信息
Immunogen sequence: MEEASEGGGN DRVRNLQSEV EGVKNIMTQN VERILARGEN LEHLRNKTED LEATSEHFKT TSQKVARKFW WKNVKMI
Highest antigen sequence identity to the following orthologs: Mouse - 95%, Rat - 92%.
靶标信息
Involved in the targeting and/or fusion of transport vesicles to their target membrane. Involved for dense-granule secretion in platelets. Plays a role in regulated enzyme secretion in pancreatic acinar cells. Involved in the abscission of the midbody during cell division, which leads to completely separate daughter cells. Involved in the homotypic fusion of early and late endosomes.
仅用于科研。不用于诊断过程。未经明确授权不得转售。
篇参考文献 (0)
生物信息学
蛋白别名: EDB; Endobrevin; synaptobrevin; VAMP-like protein; vamp; VAMP-8; VAMP5; Vesicle-associated membrane protein 8; vesicle-associated membrane protein 8 (endobrevin)
基因别名: EDB; VAMP-8; VAMP8
UniProt ID: (Human) Q9BV40
Entrez Gene ID: (Human) 8673